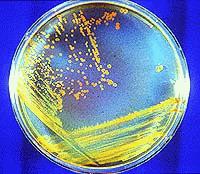

Inst. Astrobiología NASA
Por qué son importantes los microbios
Por qué son importantes los microbios
Por :Liberto Brun CompteLa investigación de posible vida microbiana en Marte puede llevarnos a adelantos en biotecnología y medicina a la vez que nos acerca más a comprender nuestros orígenes.
Por: David M. Warmflash
Es difícil especular hasta donde puede llevarnos esta nueva biología. Podemos aprender a aplicar los principios universales de la biología para entender mejor nuestro propio tipo de vida y para lograr cosas tales como el desarrollo de células artificiales, tejidos y órganos que podrían ser más satisfactorios para ciertos propósitos si los comparamos con aquéllos que sólo pueden diseñarse basados en los principios terrestres.
Como una ubicación potencial para nuestra segunda fuente de datos de biología, nuestro vecino planetario, Marte, nos llama una vez más. La posibilidad de que el experimento llevado a cabo en Marte por las dos naves Viking y divulgado en 1976 (LR), descubriera realmente microorganismos, se encuentra bajo seria discusión entre los científicos.
Se están desarrollando nuevos instrumentos para investigar el planeta, no sólo para buscar fósiles sino también para encontrar organismos vivientes actuales. Asumiendo que existen formas de vida en Marte, un examen completo nos dirá si hemos o no descubierto un tipo completamente diferente de vida.
Puede resultar que no descubramos en Marte nada más que otro ejemplo de nuestro propio tipo de vida. Podría ser que nuestro tipo de vida sea tan tenaz que se extiende fácilmente a través de espacio, montado dentro de meteoritos y cometas.
Quizás entonces, la vida no se haya originado en absoluto en nuestro planeta pero fue sembrada desde alguna otra parte. Esta posibilidad, llamada panspermia, ha obtenido algo de apoyo en años recientes debido a unos estudios que sugieren que pedazos cortos y gruesos de piedra de un planeta pueden catapultarse y depositarse en otro planeta sin llegar a calentarse al punto de que maten a cualquier microorganismo pasajero que lleven adherido.
Si los microorganismos han sobrevivido los traslados entre la Tierra y Marte, esto podría significar que las dos biosferas tienen un origen común. Si este resultase ser el caso, cabría la posibilidad de descubrir de una manera eventual un tipo de vida que se ha originado independientemente de la de la Tierra. Pero desplazaría la búsqueda para nuestro segundo grupo de datos a una ubicación más lejana, quizás a Europa, o a otros sistemas solares.
Existen posibilidades intermedias también. Quizás la panspermia dentro del Sistema solar ha ocurrido en algún tipo de vida primaria, basada en ARN y un sistema de decodificación molecular relativamente basto, como agente transmitido.
En tal caso, diferentes biosferas podrían utilizar el mismo material genético pero diferenciarse entre ellas por la forma en como se desenvuelven sus códigos genéticos. Esto sería un equivalente a tener diferentes idiomas que usasen los mismos alfabetos o similares.
Hay muchas posibilidades y cualquiera de ellas puede llevarnos potencialmente a adelantos en biotecnología y medicina mientras que, al mismo tiempo, nos acerque más a entender nuestros orígenes.
Para averiguar si el origen de la vida es frecuente en el universo, si la panspermia es frecuente, o si los dos fenómenos ocurren frecuentemente, necesitamos tener un programa sólido de exploración marciana.
Si la vida existe en Marte, nosotros necesitamos aislar los organismos reales. Si pudiera hacerse esto entonces el próximo paso sería determinar si tienen o no ADN.
Si utilizan como material genético algo diferente del ADN, entonces necesitaremos encontrar que es y como funciona. Si efectivamente usan ADN entonces necesitaremos hacer una secuencia y determinar que tanto tienen en común estos organismos con sus contrapartes terrestres.
Así que, ¿porqué importa los microorganismos marcianos? Si Marte es un planeta viviente entonces su biosfera probablemente consista totalmente de microorganismos, como sucede con el nuestro - nosotros y el resto del reino animal, junto con las plantas y los reinos de los hongos, son las excepciones raras en la Tierra que es principalmente un mundo microbial.
¡Si la base molecular de la vida marciana difiere suficientemente del equivalente terrestre para llegar a constituir un segundo dato de vida, entonces los microorganismos de Marte podrían convertirse algún día en algo tan importante para la biología como todas las especies de vida terrestre juntas!
David Warmflash es un miembro del Instituto de Astrobiología de la NASA que trabaja en el Centro Espacial Johnson en Houston, TX. Este artículo apareció primero en spacedaily.com.
JPL Planet Quest
Ciencia@Nasa
Historia de las Matemáticas
The Planetary Society
Misión Cassini-Huygens
Stephen Hawking
ESA
Misión Kepler
Glenn Research Center
Investigación NASA
Instituto SETI
Catálogo Messier
Astrobiology Magazine
Inst. Astrobiología NASA
(c) 2010 Astroseti.org
Astroseti.org es una web cuyos contenidos son proporcionados por voluntarios. Las traducciones de artículos se ofrecen bajo licencia Creative Commons. No somos responsables de los contenidos de los comentarios efectuados por nuestros usuarios, pero en caso de solicitud procederemos a su moderación, y colaboraremos en caso de comisión de falta o delito..
Club de Fans
Web gratis empresas
ayuntamientos
Lonas PVC
Máquinas de soldar
Business directory
